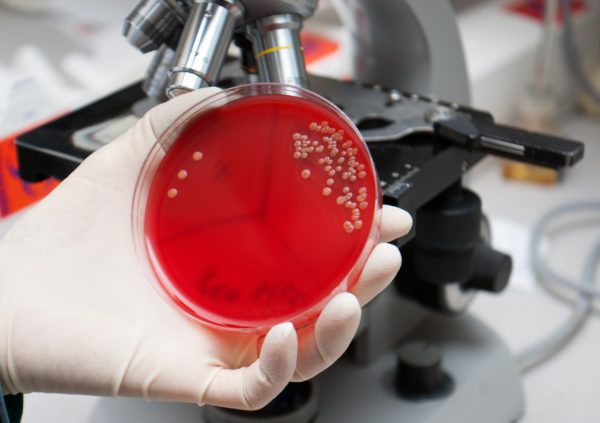

пастереллез кроликів
Пастереллез кроликів – смертельно небезпечне захворювання, і щоб не втратити все поголів'я, кролівники з великим досвідом рекомендують стежити за здоров'ям вихованців. Деякі вірусні захворювання стрімко розвиваються і вражають внутрішні органи тварини. Пастереллез відноситься до категорії швидко протікають патологічних процесів, а при відсутності оперативної терапії швидко настає смерть.
Сьогодні ми поговоримо докладніше про це захворювання, розповімо про його симптомах, особливості, лікуванні та профілактиці.

Зміст покрокової інструкції:
опис захворювання
Такий недуга, як пастерельоз часто розвивається у кроликів при зниженні опірності організму до різних вірусів. Хвороба характерна для всіх сільськогосподарських тварин. Вона зачіпає органи дихання, кролик перестає нормально дихати, у нього з'являються сильні хрипи. А також збудник проникає в органи шлунково-кишкового тракту, порушує їх функціонування, в результаті чого з'являється пронос.
Хронічна форма хвороби характеризується запаленням вуха, важкою пневмонією. Відбувається утворення абсцесів в підшкірному шарі.

Пастереллез у кролика
Як відбувається зараження?
Збудником такої інфекції, як пастерельоз, є грамнегативна бактерія. Паличка зберігається в різних умовах, так, у воді вона може перебувати близько 40 днів, а в трупах мертвих тварин знаходиться більше трьох місяців. Гине бактерія при кип'ятінні та під дією прямих променів сонця.
Виділяють наступні причини зараження:
- контакт здорового поголів'я з іншими хворими тваринами;
- на ферму вірус може потрапити через транспортний засіб, яке знаходилося на карантинній території;
- домашні тварини отримують зараження від диких птахів;
- інфекція поширюється через забруднену воду, неякісний корм;
- паличку може поширювати людина через брудні руки, при відсутності нормальної гігієни;
- бактерії поширюються через повітря, потрапляють в легені і провокують запальний процес.

Зараження відбувається вкрай швидко
Кроленята, які харчуються материнським молоком, мають особливий імунітет до таких захворювань, однак у віці 1,5 місяця вони також потрапляють в групу ризику.
Крім того, зараження схильний молодняк, який знаходиться на штучному вигодовуванні. Тому господареві доведеться уважно стежити за змінами в поведінці вихованців.
симптоми хвороби
Бактерії активно поширюються на легеневих оболонках, тому після проникнення збудника в організм, проявляється його активність протягом наступної доби. Розпізнати інфекцію на початковій формі буває досить важко. Зробити це зможе тільки досвідчений фермер і ветеринар.

Більшість кролівників не реагують на симптоми хвороби легкої форми, і це дозволяє захворюванню поширюватися по всьому організму.
Найбільш відомі симптоми інфекції:
- висока температура тіла, вище 40 градусів;
- відсутність нормальної рухливості, слабкість;
- втрата апетиту;
- здуття живота, порушення роботи травної системи;
- важке дихання;
- блювота;
- слизові виділення з очей і носа.
Кролики стають млявими, постійно сплять. Тварина починає часто терти ніс, чхає. Хворі гризуни з працею переміщаються по клітці, втрачають орієнтацію в просторі.

Пригнічений стан тварини – привід насторожитися
Такі ознаки характерні і для інших хвороб інфекційного характеру, тому важливість представляє правильна постановка діагнозу.
форми захворювання
Таблиця 1. Форми пастереллеза у кроликів
У тварин з хронічним захворюванням спостерігають формування підшкірних новоутворень. Вони розкриваються через 60-80 днів, виділяють велику кількість гною.

патологоанатомічне дослідження
Бактерії пастереллеза знаходяться на слизових оболонках і в підшкірному шарі. Після загибелі тварини, на серозних оболонках спостерігають множинні синці. Інфекція вражає практично всі внутрішні органи кролика:
- сечовидільну систему;
- лімфовузли;
- органи травлення;
- легкі;
- печінку;
- серце.

Внутрішні прояв хвороби, виявлені при розтині
Крововиливи у вигляді смужок відзначаються на трахеях. Лімфатичні вузли помітно збільшуються в розмірах. Тканини печінки піддаються некрозу. Смерть настає в результаті сильного запального процесу в легенях.
діагностика недуги
Виявити наявність патологічного процесу можна за результатами загальної діагностики: найчастіше проводять бактеріологічне дослідження фрагментів уражених органів після смерті тварини. Так можна з точністю встановити причину запальної процесу і провести ефективну терапію для всього поголів'я.
лікування пастерельозу
Така інфекція, як пастерельоз, стрімко поширюється на інших кроликів. Хвороба може спровокувати епідемію в цілому регіоні. При виявленні перших симптомів, потрібно провести обстеження всіх тварин на фермі.
Хворих тварин необхідно ізолювати в окремі клітини. Трупи кроликів спалюють. Забороняється закопувати їх у землю, інакше це спровокує повторне поширення палички.

Для лікування поголів'я використовують Сульфадимезин і антибактеріальні засоби. Найбільш ефективні препарати:
Загальний курс терапії становить 2-5 днів. Ін'єкції вводять внутрішньом'язово 2 рази на день.
При хронічній формі захворювання часто призначають наступну схему лікування:
- перші 3 дні внутрішньом'язовіін'єкції сульфаніламідних засобів;
- наступні 3 дні роблять ін'єкції антибіотиків;
- знову використовують сульфаніламідні препарати для ін'єкцій, протягом 2-3 днів.

Загальна тривалість лікування займає близько 8-10 днів. Якщо поліпшення не наступають, то тварина відправляють на забій.
Забороняється годувати м'ясом хворих кроликів інших тварин, крім того, ця продукція не повинна надходити в продаж.
Організм інфікованих тварин сильно виснажується, тому в раціоні вихованців повинні бути присутніми свіжі трави, насичені протеїном. А також для гризунів потрібно придбати спеціальні вітамінні добавки.

Тушки хворих тварин утилізують, продавати таке м'ясо заборонено
профілактика недуги
Профілактика захворювання включає дотримання наступних заходів:
- контролювати раціон вихованців;
- дотримуватися всіх норм утримання тварин на фермі;
- виключити вогкість і протяги в клітинах;
- при перших симптомах, кролика потрібно відразу ж пересадити в іншу клітку;
- встановити джерело поширення бактерій і усунути його;
- потрібно регулярно дезінфікувати годівниці, поїлки тварин, обробляти їх окропом;
- не допускати поширення щурів та інших небезпечних гризунів на фермі;
- після закупівлі молодняка, розселяти тварин в окремі клітини на тимчасовий карантин.

Клітини хворих тварин ретельно дезінфікують
Для дезінфекції кліток використовуються такі засоби:
- Формальдегід. Препарат сприяє знищенню різних бактерій, застосовувати його слід за допомогою аерозолю. Час впливу становить близько 6 годин. Залишки речовини можна видалити за допомогою аміаку.
- Білизна. За допомогою білизни слід обробити бічні стінки клітин, підлогу, а також піддон.
- Хлорамін. Випускається у вигляді порошку, який розводять з водою. Зберігати цей засіб можна до 14 днів.
- Луг. Необхідно взяти деревну золу і змішати з водою в співвідношенні 1: 3. Ємність з такою рідиною слід поставити в клітку з кролями.

Сильнодіюча луг роз'їдає металеві клітки. Тому в хімічні розчини для дезінфекції додають метасиликат натрію.Також перед заселенням молодняку в клітини, їх обробляють вогнем за допомогою газового пальника. Такий метод дозволяє швидко знищити всі бактерії.

вакцинація поголів'я
Щеплення для кроликів починають робити в 1,5 місяці, так як лише в рідкісних випадках зараження піддаються кроленята молодше цього віку. Іноді виникає необхідність у повторній ін'єкції через 2-3 тижні. На 1 кг живої маси тіла потрібно 4 мл вакцини.
Таблиця 2. Інструкція по вакцинації кроликів